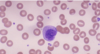

Innate Immunity Flashcards
All of the following are phagocytic cells except:
a. Macrophages
b. Dendritic cells
c. Basophils
d. Neutrophils
c. Basophils
ID the following cell:
a. Macrophage
b. Monocyte
c. Mast cell
d. NK cell

b. Monocyte
Which of the following is false regarding the cell seen in this picture?
a. They’re APC (antigen presenting cells) that secrete cytokines
b. They are long lived and connect with adaptive immunity
c. They’re known to be the first cells to respond to most bacteria and fungi
d. Their main function is phagocytosis and killing of microorganisms

c. They’re known to be the first cells to respond to most bacteria and fungi
**this is true for neutrophils and these are macrophages
Which of the following is true regarding the cell seen in this picture?
a. These are basophils, which are heavily granulated and play a role in allergies
b. These are mast cells, which contrain granules that release histamine to cause inflammation and expulse parasites
c. These are NK cells, which kill cells infected by viruses
d. These are eosinophils, which release granule contents to kill parasites and can play a role in allergies

d. These are eosinophils, which release granule contents to kill parasites and can play a role in allergies
True/False: The cell in this picture is a neutrophil which is the first cell to respond to most bacterial and fungal infections and are short lived cells.

True
Which of the following is false regarding the cell seen in this picture?
a. These cells are found in CT and near small blood vessels
b. These cells release histamine from their granules which causes inflammation
c. Their main role is to expulse parasites from the body and they can play a role in allergies
d. All the above are true

d. All the above are true
**These are mast cells
Which of the following cell is pictured?
a. Mast cell
b. Basophil
c. Eosinophil
d. NK cell

b. Basophil
This cell is the precursor to macrophages when their in the blood and they have a long lifespan.
Monocytes
What do you call a dendritic cell located in the skin? What do you call dendritic cells located in organs and lymphoid tissue?
Skin: Langerhan cells
Organs + lymphoid tissue: interstitial + interdigitating DC
What do you call macrophages that are located in the liver?
Kupfer cells
What do you call macropahges located in the CNS?
Microglial cells
Which of the following is false regarding natural killer cells?
a. They’re also known as null cells and they lack CD4, CD8 and TCR
b. They have unique killer activating and killer inhibitory receptors and CD10 receptors for immunoglobulins
c. They’re responsible for killing cells that have been infected by a virus
d. All the above are true
b. They have unique killer activating and killer inhibitory receptors and CD10 receptors for immunoglobulins
**they have CD16 receptors
All of the following cells play a role in allergies except:
a. Dendritic cells
b. Basophils
c. Eosinophils
d. Mast cells
a. Dendritic cells
What do you call macrophages that are found within the lungs?
Alveolar macrophages
Which of the following is false regarding type 1 IFN (interferons)?
a. They’re responsible for activating dendritic cells and producing IFN alpha and beta
b. They’re produced by cells already infected by a virus and will inhibit viral transcription
c. They produce other cytokines like IL-1, IL-6 and TNF
d. Also called acute phase reactant proteins produced in response to inflammation
a. They’re responsible for activating dendritic cells and producing IFN alpha and beta
**activate NK cells, which are the ones that fight against viruses
Where will you mainly find dendritic cells?
Potential portals of microbial entry (skin, lungs, GIT)
Which humoral response serves to mainly fight agianst bacterial infections by altering and recruiting macrophages to lyse the bacteria?
Complement
What do you call macrophages that are found within the bone?
Osteoclasts
True/False: Epithelial cells are your second line of defense and WBC’s are the first line of defense.
False
**other way around, Epithelial’s are first line of defense and WBC are second line of defense
What are the five cardinal signs of inflammation?
Heat
Swelling
Redness
Pain
Loss of function
Which chemokine do phagocytic neutrophils respond to?
IL-8
Which of the following is false regarding cytokines and chemokines?
a. They can act locally and systemically and can lead to inflammation
b. TNF alpha and IL-1 are cytokines that can change the morphology of cells
c. Chemokines are chemoattractants of other cells
d. All the above are true
d. All the above are true
True/False: Tethering and rolling is mediated by integrins.
False
**mediated by selectins
Lysosomal enzymes indirectly kill microbes by making what two things?
ROS and Nitric Oxide
Pattern recognition receptors are expressed by each of the following cells except:
a. Macrophages
b. T lymphocytes
c. Neutrophils
d. None of the above
b. T lymphocytes
True/False: Neutrophils are usually the frist leukocytes to arrive at a site of inflammation
True
Components of innate immunity include all the following except:
a. Epithelial barriers
b. Antibody
c. Phagocytes
d. Natural killer cells
b. Antibody
Which of the following applies to interleukin-1?
a. Hepatocytes consistute a major source of IL-1
b. IL-1 promotes endothelial expression of cell adhesion molecules
c. IL-1 is a potent microcidal agent
d. None of the above
b. IL-1 promotes endothelial expression of cell adhesion molecules
Regarding macrophages, which of the following statements is least accurate?
a. Macrophages are derived from monocytes
b. Neutrophils follow monocytes as an early cellular component of acute inflammation
c. Macrophages are long lived cells
d. Macrophages secrete cytokines to activate and promote innate and adaptive immune responses.
b. Neutrophils follow monocytes as an early cellular component of acute inflammation
Which cell processes antigens and presents antigenic peptides to T cells?
a. Neutrophils
b. Mast cells
c. Eosinophils
d. Denditic cells
d. Denditic cells
Componentes of innate immunity that provide the first line of defense against microbial invasion includes all the following except:
a. Tissue macrophages
b. Cilia
c. Mucous
d. Epithelial barriers
a. Tissue macrophages